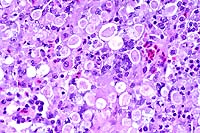
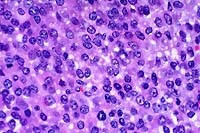

Results
AFIP Wednesday Slide Conference - No. 16
January 13, 1999
- Conference Moderators:
Dr. Richard J. Montali and Dr. James T. Raymond
Department of Pathology
National Zoological Park Washington, D.C. 20008
-
- NOTE: Click on images for larger views. Use
browser's "Back" button to return to this page.
Return to WSC Case Menu
-
- Case I - 98-317-7 (AFIP 2652613)
-
- Signalment: A 23-year-old, female, Matschie's tree
kangaroo (Dendrolagus matschiei).
-
- History: This animal originated from a breeding colony
of tree kangaroos held at the National Zoological Park Conservation
& Research Center in Front Royal, Virginia. The animal had
a chronic history of coughing and had been treated for mycobacteriosis
for the past four years. In September of 1998, she was moved
to a new area at the research center. Her eating habits became
erratic, and she developed gastric bloating and died after a
surgical procedure to relieve the gas accumulation.
-
- Gross Pathology: At necropsy, the animal presented
in good nutritional condition with adequate subcutaneous and
cavitary fat. Externally, a small amount of a cloudy, serous
fluid was dripping from the left naris, and a circumscribed,
firm mass measuring 1.0 x 0.75 centimeters was found at the base
of the left teat; it contained a firm, gritty, yellow material.
Internally, there was petechiation of the serosa and intestines,
and the spleen was diffusely dark black. The pleurae were diffusely
opaque, moderately thickened, and there were multiple, stringy,
fibrous attachments between the parietal and visceral pleura.
The upper left lung lobe was severely consolidated, mottled pink,
red, and yellow, and contained multiple, white, nodules measuring
up to 7 millimeters in diameter which were filled with a creamy
discharge when cut. The remaining lung lobes were mottled dark
red and pink. The bronchial lumens occasionally contained casts
of green, pasty material that extended to the level of the bronchioles.
-
- Laboratory Results: Mycobacterium avium was cultured
from the lungs.
-
- Contributor's Diagnosis and Comments: Lung, pneumonia,
caseonecrotic, cavitating.
Etiology: Mycobacterium avium.
The National Zoological Park has maintained a breeding colony
of Matschie's tree kangaroos (Dendrolagus matschiei) since 1975
with a documented history and continued prevalence of Mycobacterium
avium complex (MAC) infections. No evidence of immunosuppressive
retrovirus infections or loss of heterozygosity that may have
led to an immune dysfunction in these animals was found. Isolates
of MAC organisms from affected tree kangaroos and from their
environment had no common restriction fragment DNA types. Cellular
immune reactivity in apparently healthy tree kangaroos was three
to six-fold lower than in humans and other marsupial and eutherian
mammals, as determined by lymphocyte proliferative assays. Thus,
while MAC infections are typically opportunistic in humans and
other mammals, tree kangaroos commonly develop primary progressive
disease with MAC from random sources. Comparative information
derived from this study should benefit both the endangered tree
kangaroo and humans with immunosuppressive disorders that lead
to mycobacterial infections.
 2x
obj
2x
obj
- Case 16-1. Lung. Central area of cavitary necrosis
is surrounded by congested, consolidated lung parenchyma.
 40x
obj, Ziehl-Nielson Stain
40x
obj, Ziehl-Nielson Stain
- Case 16-1. Lung. Numerous acid fast bacilli are scattered
throughout caseous necrotic debris.
- AFIP Diagnosis: Lung: Pneumonia, granulomatous and
necrotizing, diffuse, severe, with cavitation and mineralization,
Matschie's tree kangaroo (Dendrolagus matschiei), marsupial.
-
- Conference Note: Marsupials are more susceptible to
infection with mycobacteria than true placental mammals, and
the earliest report of a tuberculous disease in a captive tree
kangaroo was described in the middle of the 19th century. More
recently, a number of Mycobacterium avium complex (MAC) infections
have been documented in several managed colonies of tree kangaroos
in North America. The prevalence of MAC infections of marsupials
in the wild is currently unknown.
-
- Disease due to MAC in captive Matschie's tree kangaroos begins
insidiously and progresses over a period of two to three years.
The disease predominantly affects males that are between the
ages of 5 and 16 years, with a reported male to female ratio
of 3:2. Clinical signs vary from none to lethargy, anorexia,
and weight loss; coughing is occasionally reported, but is not
a prominent sign in most animals. Radiographic evidence of pneumonia
is present in advanced cases, and cytological evaluation of tracheobronchial
lavage samples sometimes reveals the presence of inflammatory
cells admixed with filamentous acid-fast bacilli.
-
- In the group of diseased tree kangaroos studied by the contributor,
gross and microscopic lesions due to MAC infection have been
observed in several organ systems. However, the most extensive
lesions have occurred in the lungs and bones, and were histologically
characterized by necrotizing pyogranulomatous pneumonia and osteomyelitis
with numerous acid-fast bacilli. The Ziehl-Neelsen and Fite's
staining methods performed at the AFIP demonstrated acid-fast
bacilli in a section of lung from this tree kangaroo.
-
- The recent study cited by the contributor indicates that
tree kangaroos in captivity are very sensitive to MAC infections.
Infected animals often develop progressive pulmonary mycobacteriosis
that may disseminate and become fatal. The in vitro studies examining
lymphocyte responses in healthy tree kangaroos seem to indicate
that cellular immune reactivity is lower in this species compared
to other marsupials and eutherian mammals resistant to MAC infections.
This lowered cell-mediated immune response may significantly
contribute to the susceptibility to opportunistic MAC infections
in tree kangaroos. However, tree kangaroos do not appear to be
predisposed to other opportunistic infections, and there may
be additional factors which contribute to increased susceptibility
to MAC, including genetic influences, stress, and environmental
exposure. Additionally, the respiratory tracts of many tree kangaroos
have been found to be colonized with mycobacteria, but some animals
remain asymptomatic for more than three years; this is another
unusual feature of MAC disease in Matschie's tree kangaroos.
- Contributor: National Zoological Park, Department
of Pathology, 3001 Connecticut Ave. NW, Washington D.C. 20008.
-
- References:
- 1. Montali RJ, Bush M, Cromie R, et al.: Primary Mycobacterium
avium complex infections correlate with lowered cellular immune
reactivity in Matschie's tree kangaroo (Dendrolagus matschiei).
J Infect Dis 178(6), 1998 (in press).
-
-
- Case II - UCD 1 (AFIP 2648197)
-
- Signalment: Five-month-old, female, black-tailed deer
(Odocoileus hemionus columbianus).
-
- History: This fawn was experimentally infected with
deer adenovirus isolated from a naturally infected fawn in Yuba
County, California that died during the 1993 epizootic of adenovirus
hemorrhagic disease. The adenovirus was isolated in black-tailed
deer pulmonary artery endothelial cells, purified on a CsC1 gradient,
and dialyzed in PBS. This female fawn was inoculated by intravenous
injection and died five days post-inoculation.
-
- Gross Pathology: Necropsy findings included blood-stained
perineum, hemorrhage throughout the lumen of the small and large
intestines, and pulmonary edema. Color photo transparencies of
the lungs and intestinal tract are included.

- Case 16-2. Lung. Interlobular septa are markedly expanded
by edema fluid.

- Case 16-2. Spiral colon and jejunum. Colon & small
intestine is segmentally filled with dark red hemorrhage-stained
ingesta. The mesentar appears diffusely edematous.
-
- Laboratory Results: Fluorescent antibody test using
fluorescence-labeled bovine antiserum to bovine adenovirus type
5 (BAV-5) and immunohistochemistry using BAV-5 antiserum stained
endothelial cell nuclei in the lungs, alimentary tract, lymph
nodes, and other organs.
-
- Contributor's Diagnoses and Comments:
- 1. Pulmonary vasculitis with endothelial hypertrophy, necrosis,
and intranuclear inclusion bodies.
- 2. Interstitial pneumonia, moderate, acute, lymphocytic,
neutrophilic, with pulmonary edema.
Etiology: Adenovirus.
-
- Ten fawns were inoculated with adenovirus, half of which
were inoculated through the mucous membranes and the other half
intravenously. Eight fawns developed clinical disease with either
systemic or the localized form of the disease. Lesions reproduced
were similar to those described in black-tailed deer that died
during the natural epizootic that occurred in California in 1993.
The epizootic started in July of 1993 and continued into the
spring of 1994. Thousands of deer were believed to have died
during this outbreak. Other than two outbreaks in rehabilitation
centers, no other cases were reported in California until July
of 1998. Adenovirus has thus far been confirmed in deer from
three counties in California associated with high mortality in
free ranging deer herds. In addition, adenovirus has been confirmed
associated with increased mortality in farmed white-tailed deer
in Iowa.
-
- In the tissue section of this experimentally infected animal,
the pulmonary parenchyma is multifocally atelectatic, and the
interlobular septa and subpleural spaces are moderately to severely
expanded by edema and very mild inflammation (lymphocytes, plasma
cells, and neutrophils). Small to medium-sized arterioles throughout
the tissue are lined by endothelium in which the nuclei are prominent
and rounded, are darkly basophilic, bulge into the vascular lumina,
and contain darkly amphophilic viral inclusion bodies. Many of
these arterioles contain sloughed luminal endothelial cells admixed
with moderate numbers of mononuclear and polymorphonuclear cells,
and in some of the arterioles, inflammation extends into the
vessel wall where it is admixed with rare, brightly eosinophilic
hyalinized material (fibrinoid necrosis). Throughout the remaining
parenchyma there is multifocal atelectasis, alveolar capillaries
are expanded by neutrophils, and there is expansion of alveolar
septa by moderate numbers of neutrophils and lymphocytes. Transmission
electron microscopy demonstrated endothelial cell necrosis in
the lungs and alimentary tract and adenovirus particles in the
nuclei with protein crystalline arrays.
-
- Differential diagnosis should include the orbiviruses, bluetongue
virus and epizootic hemorrhagic disease virus. Definitive diagnosis
depends on the presence of endothelial intranuclear inclusions
in the lungs with the systemic adenoviral infection. Transmission
electron microscopy or immunohistochemistry demonstrates adenovirus
in endothelial cells in the lungs, alimentary tract, and other
organs. Animals with the localized form of the disease may die
of starvation or bacterial sepsis with chronic lesions in the
upper alimentary tract. Finding inclusions or virus by transmission
electron microscopy or immunohistochemistry in chronic lesions
is more difficult.
 TEM
TEM
- Case 16-2. Transmission Electron Micrograph. The cytosol
is expanded by electron dense hexagonal particles (virions) layered
between multiple needle-like crystal lattices of moderately electron
dense granular material.
 20x
obj
20x
obj 40x
obj
40x
obj
- Case 16-2. Lung. The pulmonary arteriole (20x view)
is expanded by lymphocytes and plasma cells. The endothelium
(both views) is lined by piled up, hypertrophic, endothelial
cells which rarely bear smudgy amphophilic intranuclear inclusions
(arrow head).
- AFIP Diagnosis: Lung: Endothelial degeneration and
hypertrophy, diffuse, with multifocal vasculitis, interstitial
pneumonia, diffuse edema, and endothelial intranuclear inclusion
bodies, black-tailed deer (Odocoileus hemionus columbianus),
cervid.
Note: A fat embolus was observed in some sections.
-
- Conference Note: A novel adenovirus closely related
to bovine adenovirus-5 was identified as the cause of the 1993
epizootic of hemorrhagic disease of mule deer (Odocoileus hemionus)
in California. The gross and histologic lesions of systemic adenovirus
in mule deer are remarkably similar to the those found in the
hemorrhagic disease of white-tailed deer (Odocoileus virginianus)
caused by orbiviruses (bluetongue virus and epizootic hemorrhagic
disease virus). Outbreaks of hemorrhagic disease in mule deer
in California previous to 1993 were attributed to bluetongue
but may have been caused by deer adenovirus. As noted by the
contributor, the presence of endothelial intranuclear inclusions
distinguishes adenovirus from orbivirus infection in deer presenting
with signs of hemorrhagic disease. Additionally, hemorrhage in
deer caused by orbivirus appears to be more widespread, while
hemorrhage and edema seem to be confined to the lung and intestinal
tract in adenoviral infections.
-
- The most significant gross pathologic findings in deer with
natural and experimental systemic adenovirus infections are pulmonary
edema and hemorrhagic enteropathy. The virus consistently infects
the endothelial cells of the lungs and intestines, causing endothelial
necrosis associated with intranuclear inclusions. Disruption
of the endothelium leads to hemorrhage and edema. Endothelial
necrosis exposes the subjacent basement membrane, triggering
platelet adhesion and agglutination that may culminate in disseminated
intravascular coagulation. The endotheliotropic character of
this strain of adenovirus resembles that of bovine adenovirus-10,
infectious canine hepatitis virus, and porcine adenovirus. Localized
vasculitis with necrotizing stomatitis, pharyngitis, glossitis,
and/or osteomyelitis of the jaw were other lesions frequently
found in mule deer that died during the 1993 California epizootic.
-
- Diseases caused by adenoviruses in other species are most
often observed in neonatal or juvenile animals, or in immunocompromised
individuals. Mule deer with clinical disease caused by adenovirus
in the 1993 California epizootic were predominantly fawns, though
a few juveniles and adults were also affected. Adenovirus or
adenovirus-like infection has been reported in a red deer from
New Zealand and a fallow deer in Hungary, but the viruses in
these cases primarily targeted the bronchiolar epithelium and
are likely a different strain of adenovirus from the one associated
with hemorrhagic disease of deer in California.
-
- Contributor: California Veterinary Diagnostic Laboratory
Services, School of Veterinary Medicine, University of California,
PO Box 1770, Davis, CA 95617.
-
- References:
- 1. Woods LW, et al.: Systemic adenovirus infection associated
with high mortality in mule deer (Odocoileus hemionus) in California.
Vet Pathol 33:125-132, 1996.
- 2. Woods LW, et al.: Experimental adenovirus hemorrhagic
disease in yearling black-tailed deer. J Wildl Dis 33:801-811,
1997.
- 3. Woods LW, et al.: Lesions and the transmission of experimental
adenovirus hemorrhage disease in black-tailed deer fawns (in
press), 1998.
-
-
- Case III - 537-98 (AFIP 2656747)
-
- Signalment: Seven-week-old broiler breeder pullets
(chicken).
-
- History: There was increased mortality of 3-4 days
duration. Affected birds were lethargic, inappetent, and had
ruffled feathers and mild to moderate loss of pectoral muscle
mass. A few birds had red-brown feces.
-
- Gross Pathology: Moderate to marked loss of pectoral
muscle mass was present. Gross lesions varied with chronicity,
ranging from marked hyperemia and mild ulceration of the cecal
mucosa to extensive ulceration of the cecal mucosa with large
fibrinonecrotic casts within the lumens. In virtually all birds,
there was moderate to marked thickening of the cecal walls. The
livers of several birds contained variably-sized, often coalescing,
foci of necrosis. In a few of the birds, there was rupture of
the cecum with extensive fibrinous peritonitis and airsacculitis.
Small numbers of cecal worms (Heterakis gallinarum) were variably
present in the cecal lumen.
-
- Laboratory Results: Clinical pathology was not performed.
Liver cultures revealed a mixed aerobic growth including moderate
numbers of Escherichia coli and a variety of other bacteria.
Salmonella sp. were not isolated.
-
- Contributor's Diagnoses and Comments:
- 1. Cecum: Ulcerative, lymphocytic, histiocytic typhlitis,
multifocal to coalescing, subacute, severe with intralesional
protozoa and intraluminal nematodes.
- 2. Liver: Necrotizing, lymphocytic, histiocytic hepatitis,
multifocal to coalescing, acute to subacute, severe, with intralesional
protozoa.
Etiology: Histomonas meleagridis and Heterakis gallinarum.
-
- While typically associated with morbidity and mortality in
turkey flocks, infections with Histomonas meleagridis have caused
significant morbidity and mortality in young broiler breeder
flocks (pullets and cockerels) in recent months. The exact cause
of this recent re-emergence is not clear, however. Factors including
changes in anticoccidial programs and availability of antiprotozoal
drugs may have contributed to these outbreaks.
 10x
obj
10x
obj 40x
obj
40x
obj
- Case 16-3. Liver. Liver parenchyma is multifocally
necrotic and partially replaced by myriad Histomonas trophozoites,
10-20u in diameter, which are fragmented, pale, amphophilic,
and surrounded by narrow rims of clear space.
 20x
obj
20x
obj 40x
obj
40x
obj
- Case 16-3. Colon. The lamina propria is diffusely
expanded by macrophages, lymphocytes, heterophils, and fragmented,
pale, granular Histomonas amoeba. At points of mucosal erosion,
these inflammatory cells stream into the gut lumen.
AFIP Diagnoses:
- 1. Liver: Hepatitis, granulomatous, necrotizing, multifocal
to coalescing, moderate, with numerous protozoa, chicken, avian.
- 2. Cecum: Typhlitis, lymphoplasmacytic, histiocytic, and
heterophilic, diffuse, moderate, with protozoa and cecal core.
- Some microslides contain cross-sections of intraluminal cecal
nematodes.
-
- Conference Note: Histomoniasis, caused by the protozoan
Histomonas meleagridis, is a disease of several gallinaceous
birds including turkeys, chickens, peafowl, grouse, quail, and
other species. Major lesions in infected and clinically diseased
birds are necrotizing hepatitis and typhlitis. The disease has
been referred to as infectious enterohepatitis and "blackhead"
in turkeys. Bacteria, such as Clostridium perfringens, seem to
play a pivotal role in the pathogenesis of the disease, and experimentally,
in the absence of bacteria, the histomonad does not appear to
be pathogenic.
-
- Histomoniasis is a ubiquitous disease. Infected chickens
often have only mild illness. Chickens serve as the principal
reservoir of infection for turkeys, which are extremely susceptible
and often succumb to the disease. Turkey poults between 3 and
12 weeks of age and chickens between 4 and 6-weeks-old are the
most susceptible to infection. The chukar partridge and ruffed
grouse are also severely affected. Milder forms of disease occur
in peafowl, guinea fowl, bobwhite quail, and pheasants. While
development of safe antihistomonal drugs has significantly limited
disease in domestic poultry, histomoniasis remains an important
cause of death among many other galliformes.
-
- Transmission of H. meleagridis to susceptible birds may occur
by one of three mechanisms. First, birds may ingest fresh feces
containing histomonads; this route is probably unimportant with
the exception of spread among closely confined animals within
a flock. Second, birds may ingest embryonated eggs of the ascarid
cecal nematode Heterakis gallinarum which contain the histomonads.
The protozoa are liberated from the nematode eggs when the larvae
break out, and the histomonads subsequently invade the cecal
wall. Protozoa are then carried to the liver via the hepatic
portal system. Finally, birds may become infected through ingestion
of earthworms containing histomonad-bearing cecal worm larvae
in their tissues. Interestingly, histomoniasis occurs infrequently
in areas lacking earthworms or other mechanical vectors, or in
areas with sandy, dry soil. Historically, infection in turkeys
occurred when the animals were reared together with chickens,
or when raised on ground previously inhabited by chickens. Histomonads
may survive several years within cecal worm eggs.
-
- The classical macroscopic lesions of histomoniasis include
bilaterally enlarged, hemorrhagic ceca that have a thickened
mucosa and are filled by caseo-necrotic, yellow-green, laminated
material (cecal cores). The cecal mucosa may also be necrotic
and ulcerated. In the liver, there are multifocal to coalescing,
circular, depressed, greenish-yellow areas of necrosis that are
circumscribed by a thin raised ring of parenchyma. The hepatic
lesions have been described as target-like. Microscopically,
the histomonads can be identified within areas of inflammation
in the cecae and within necrotic areas of the liver on routine
hematoxylin and eosin stained sections. Visualization of the
protozoal trophozoites may be enhanced by the periodic acid-Schiff
reaction, especially in chronic lesions that contain few organisms.
-
- Contributor: Laboratories of Veterinary Diagnostic
Medicine, University of Illinois, 2001 South Lincoln Ave., Urbana,
IL 61801.
-
- References:
- 1. American Association of Avian Pathologists Committee on
Disease Reporting: 1986 summary of commercial poultry disease
reports and 1986 pet, zoo, and wild bird disease report. Avian
Dis 31:926-987, 1987.
- 2. McDougald LR: Other protozoan diseases of the intestinal
tract. In: Diseases of Poultry, Calnek BW, ed.,10th ed., pp.
890-899, Iowa State University Press, Ames, Iowa, 1997.
- 3. Kemp RL, Reid WM: Staining techniques for differential
diagnosis of histomoniasis and mycosis in domestic poultry. Avian
Dis 10:357-363, 1966.
- 4. Lee DL: The structure and development of Histomonas meleagridis
(Masticamoebidae: protozoa) in the female reproductive tract
of its host, Heterakis gallinae (nematoda). Parasitol 59:877-884,
1969.
- 5. Charlton BR, et al.: Histomoniasis. In: Avian Disease
Manual, 4th ed., pp. 178-180, American Association of Avian Pathologists,
University of Pennsylvania New Bolton Center, PA, 1996.
-
-
- Case IV - V98-7693 (AFIP 2643018)
-
- Signalment: Five-year-old, male, hedgehog.
-
- History: Lethargy, weak hind limbs, and a fifty gram
weight loss were noted over one year. Physical examination revealed
a caudal abdominal mass, which on exploratory laparotomy, was
not associated with the gastrointestinal tract, liver, kidneys,
or bladder. Multiple small omental masses were noted.
-
- Gross Pathology: The caudal abdominal mass measured
1 x 2.7 x 3 centimeters and was firm and irregular. The omental
masses were 1-3 millimeters in diameter and were disseminated
throughout the omentum.
-
- Laboratory Results: None.
-
- Contributor's Diagnoses and Comments:
- 1. Testicle: Interstitial cell tumor, with multifocal infarction.
- 2. Testicle: Moderate to severe diffuse atrophy of seminiferous
tubular epithelium, multifocal mineralized intratubular debris
and occasional spermatozoa.
- 3. Omentum: Metastatic interstitial cell tumor.
-
- Interstitial cell tumors (ICT) are derived from Leydig cells
and rarely metastasize. A continuum was noted from a less well
differentiated cell type which had a hyperchromatic central round
nucleus and a modest amount of a lightly basophilic cytoplasm,
to larger round polyhedral cells with abundant lightly eosinophilic
to vacuolated cytoplasm in the more well differentiated cells.
There was mild cytomorphologic atypia and a slightly higher mitotic
rate (2-4/hpf) in well differentiated areas of the tumor. The
sharply demarcated focus of tumor necrosis is suggestive of vascular
compromise due to possible tumor emboli. Numerous tumor metastases
were noted in the omentum. The mineralized debris in the seminiferous
tubules appeared to obstruct flow, trapping the few spermatozoa
present in the nearby tubules resulting in mild distention.
-
- Hedgehogs are popular exotic pets in which neoplasia is quite
common. However, reference material is rather scarce. There are
a few isolated case reports in the literature1, 2 and one review
of hedgehog necropsy lesions from the Baltimore Zoo from 1984-1991.3
Thirty-two percent of 74 hedgehogs necropsied at the Baltimore
Zoo from 1984-1991 had neoplasms. Neoplasia was common in the
integumentary, respiratory, reproductive, hematopoietic, and
endocrine systems.3 Multiple skeletal sarcomas have been associated
ultrastructurally with probable type C retrovirus in two African
hedgehogs.
-
- Interstitial cell tumors are common in older animals and
in cryptorchid testicles. Hedgehog testicles are often located
intra-abdominally. Interstitial cell tumors are classified as
solid diffuse, cystic vascular, and pseudoadenomatous. This interstitial
cell tumor (ICT) is an intermediate type between the solid diffuse
and cystic vascular types. The atrophic seminiferous tubules
may have been a result of mechanical obstruction, an aging change,
seasonal variation, or less likely, humoral inhibition.
 4x
obj
4x
obj 40x
obj
40x
obj
- Case 16-4. Testis, Epididymis. Replacing seminiferous
tubules and extending around adjacent epididymal tubules, there
is an expansile, infiltrative mass consisting of sheets of polygonal
cells bearing pale granular, often vacuolated cells with oval
to round nuclei with granular basophilic chromatin.
 20x
obj
20x
obj
- Case 16-4. Testis. Seminiferous tubules are atrophic,
lack mature spermatozoa, and contain reduced numbers of spermatids.
Tubules are separated by clear space (edema) and free RBCs (hemorrhage).
 4x
obj
4x
obj
- Case 16-4. Mesentary. Multifocally expanding mesothelium
lined adipose tissue, there are numerous irregularly sized nodules
of pleomorphic polygonal cells like those described above (metastatic
foci).
- AFIP Diagnoses:
- 1. Testis: Interstitial cell tumor, malignant, hedgehog,
insectivore.
- 2. Adipose tissue (omentum per contributor): Interstitial
cell tumor, malignant, metastatic.
-
- Conference Note: A densely cellular neoplasm has effaced
the testis and infiltrated the epididymis. It is composed of
polygonal cells arranged in broad cords, nests, packets and solidly
cellular areas, supported by a fine fibrovascular stroma. In
some areas, neoplastic cells palisade along the vascular stroma.
Neoplastic cells have indistinct cell borders, moderate amounts
of eosinophilic cytoplasm, and oval to elongate nuclei. Some
polygonal cells contain very distinct, clear, cytoplasmic vacuoles.
The mitotic rate is high, and some mitotic figures are bizarre.
Similar neoplastic cells are found within the submitted sections
of mesentery. Based on histomorphology, conference participants
agreed with the contributor's diagnosis. The differential diagnosis
that was considered included seminoma, Sertoli cell tumor, lymphoma,
mast cell tumor, and mesothelioma.
-
- Among domestic species, testicular tumors occur most commonly
in geriatric dogs, are found less frequently in aged bulls and
stallions, and are unusual or rare in other animals such as cats,
sheep, and swine. The three most common testicular tumors are
seminoma, interstitial cell tumor and Sertoli cell tumor, and
they arise, respectively, from germ cells, interstitial (Leydig)
cells, and Sertoli (sustentacular) cells. In the dog, cryptorchidism
is an important predisposing factor for development of seminomas
and Sertoli cell tumors. Cryptorchidism is not a recognized predisposing
condition for development of interstitial cell tumors, except
in the horse and possibly the cat. Interestingly, most interstitial
cell tumors in the horse occur in cryptorchid testes.
-
- Leydig cells normally produce androgens, and interstitial
cell tumors in humans may elaborate excess androgens and/or estrogens,
and occasionally corticosteroids. Most canine interstitial cell
tumors do not produce excess hormones. Hormonally active canine
interstitial cell tumors are associated with perianal gland hyperplasia,
prostatic enlargement, and tail-gland hyperplasia, suggesting
androgen excess. Less frequently, signs of hyperestrogenism may
occur including alopecia and attraction of other male dogs.
-
- Contributor: Marshfield Laboratories, 1000 North Oak
Avenue, Marshfield, WI 54449.
-
- References:
- 1. Raymond JT, et al: Malignant mast cell tumor in an African
hedgehog. J Wildl Dis 33:140-142, 1997.
- 2. Rivera RY, et al: Oronasal squamous cell carcinoma in
an African hedgehog. J Wildl Dis 28:148-150, 1992.
- 3. Done LB, et al: Necropsy lesions by body systems in African
hedgehogs. In: Proceedings of the Annual Meeting of American
Association of Zoo Veterinarians, pp. 113-115, Oakland, CA, 1992.
- 4. Peauroi JR, et al: Multicentric skeletal sarcomas associated
with probable retroviral particles in two African hedgehogs.
Vet Pathol 31:481-484, 1994.
- 5. Ladds PW: The male genital system. In: Pathology of Domestic
Animals, Jubb KVF, Kennedy PC, Palmer N, eds., 4th ed., volume
3, pp. 504-511, Academic Press, San Diego, CA, 1993.
- 6. Kennedy PC, et al.: Histological classification of tumors
of the genital system of domestic animals. In: World Health Organization
International Histological Classification of Tumors of Domestic
Animals, Schulman FY, ed., Second series, volume 6, pp. 15-19,
Armed Forces Institute of Pathology and American Registry of
Pathology, Washington DC, 1998.
-
- Conference Coordinator:
-
- Ed Stevens, DVM
Captain, United States Army
Registry of Veterinary Pathology*
Department of Veterinary Pathology
Armed Forces Institute of Pathology
(202)782-2615; DSN: 662-2615
Internet: STEVENSE@afip.osd.mil
-
- * The American Veterinary Medical Association and the American
College of Veterinary Pathologists are co-sponsors of the Registry
of Veterinary Pathology. The C.L. Davis Foundation also provides
substantial support for the Registry.
- Return to WSC Case Menu
 2x
obj
2x
obj
 40x
obj, Ziehl-Nielson Stain
40x
obj, Ziehl-Nielson Stain


 TEM
TEM
 20x
obj
20x
obj 40x
obj
40x
obj
 10x
obj
10x
obj 40x
obj
40x
obj
 20x
obj
20x
obj 40x
obj
40x
obj
 4x
obj
4x
obj 40x
obj
40x
obj
 20x
obj
20x
obj
 4x
obj
4x
obj